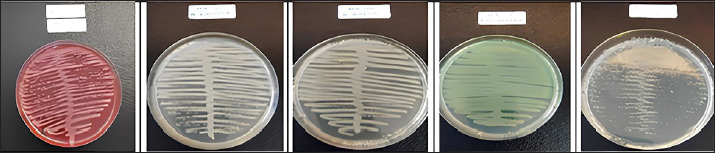

| Research Article | ||
Open Vet. J.. 2025; 15(3): 1379-1386 Open Veterinary Journal, (2025), Vol. 15(3): 1379-1386 Research Article Effectiveness of predatory bacterium Bdellovibrio bacteriovorus in combination with Pseudomonas fluorescens and Lactobacillus acidophilus as candidates for in vitro anticolibacillosisEduardus Bimo Aksono1, Muchammad Yunus1*, Iwan Sahrial Hamid1 and Gadis Meinar Sari21Division of Basic Veterinary Medical Sciences, Department of Veterinary Medicine, Faculty of Veterinary Medicine, Universitas Airlangga, Surabaya, Indonesia 2Division of Veterinary Parasitology, Department of Veterinary Medicine, Faculty of Veterinary Medicine, Universitas Airlangga, Surabaya, Indonesia *Corresponding Author: Muchammad Yunus. Department of Veterinary Science, Faculty of Veterinary Medicine, Universitas Airlangga, Surabaya, Indonesia. Email: muchammad-y [at] fkh.unair.ac.id Submitted: 22/12/2024 Accepted: 05/02/2025 Published: 31/03/2025 © 2025 Open Veterinary Journal
AbstractBackground: Bdellovibrio bacteriovorus has stood out since its initial discovery because of its exceptional capacity to feed on other Gram-negative bacteria. Since this specific “predatory bacterium” may be used as both a probiotic and an antibiotic, research on it has expanded in response to the growing issue of Antimicrobial Resistance (AMR). It is necessary to investigate the relationship between B. bacteriovorus and other Gram-negative bacteria, as well as the presence of Gram-positive bacteria, in the same environment to determine whether or not these factors have an impact on their ability as predators. Aim: This study aimed to assess the effectiveness of the combination of the predatory bacterium B. bacteriovorus with Pseudomonas fluorescens and Lactobacillus acidophilus as potential candidates for in vitro anticolibacillosis. Methods: The method employed Escherichia coli ATCC 15144 as the prey, while B. bacteriovorus 109 J ATCC 15143 was used as the predator, combined with P. fluorescens and L. acidophilus as the nutrient sources of the predator. In the challenge experiment, a ratio of the bacterial combination was used to optimize predation to E. coli of 107 PFU/105 CFU per ml. Results: The study showed that the combination of B. bacteriovorus with P. fluorescens and L. acidophilus after 24 hours of in vitro incubation at 37°C increased the predatory bacteria count by tenfold, effectively reducing the E. coli population. However, in the absence of Gram-negative bacteria as a nutrient source, the predator population gradually declined. Conclusion: The combination of B. bacteriovorus as a predatory bacterium with P. fluorescens and L. acidophilus is an effective candidate for in vitro anticolibacillosis. Keywords: B. bacteriovorus, P. fluorescens, L. acidophilus, Anticolibacillosis, in vitro. IntroductionColibacillosis is a major cause of mortality (up to 20%) and morbidity in poultry, resulting in significant losses in meat production (2% live weight decrease, 2.7% decrease in feed conversion ratio), decreased egg yield (up to 20%), decreased hatchability rates, and decreased carcass percentage (up to 43%) by the time it is slaughtered (Kathayat et al., 2021). This disease is caused by the pathogenic Gram-negative Escherichia coli bacterium, which is a facultative anaerobic bacterium that poses a persistent and economically detrimental threat to poultry farmers (Abalaka et al., 2017; Rybak et al., 2022; Kika et al., 2023). Although E. coli is frequently found in the avian digestive system as a commensal bacteria, not all strains are pathogenic (Rybak et al., 2017). Environmental variables, host immune response, and pathogen virulence interact in a complicated manner to affect the clinical manifestation of colibacillosis (Weerts et al., 2021), causing significant morbidity and mortality, ranging from gastrointestinal and respiratory infections to serious systemic diseases. Avian pathogenic E. coli (APEC) is responsible for mortality rates as high as 53.5% in young poultry (Mellata, 2013). With losses estimated to be hundreds of millions of dollars every year, APEC has a huge financial impact on the world’s poultry sector (Ghunaim et al., 2014). In the United States alone, APEC-related carcass condemnations cost the broiler industry approximately $40 million per year (De Brito et al., 2003). According to recent studies, APEC, namely isolates from sequence types ST95 and ST131, or serogroup O1, O2, and O18, is linked to colibacillosis in chickens and can serve as a source or reservoir of extraintestinal illnesses in humans in addition to being a zoonotic foodborne pathogen (Koutsianos et al., 2022). The virulence characteristics of these serogroups may vary, such as their capacity to adhere to the intestinal epithelium and infiltrate host organs (Koutsianos et al., 2022). Pathogenic strains acquire specific virulence factors, such as adhesions, toxins, and invasions (Sora et al., 2021), allowing bacteria to cling to the tissues of the host, colonize different organs, and avoid the host’s immune system. Fimbriae (pili), outer membrane proteins, and toxins, including cytotoxins, hemolysins, and endotoxins are examples of common virulence factors (Meena et al., 2019). Key factors in modern animal production include disease prevention, improved growth rates, and enhanced feed conversion efficiency (Kostadinović and Lević, 2018). One approach to achieving these goals has been the use of antibiotics. Antibiotics are frequently used in chicken nutrition as a preventive measure to boost growth, improve feed intake and utilization, and reduce clinical illness mortality (Kostadinovic et al., 2001). However, since 2006, the European Union has prohibited the use of antibiotic growth promoters (AGPs) in livestock due to rising concerns about the spread and transmission of antibiotic-resistant bacteria through the food chain (Kostadinović and Lević, 2018). In early 2018, Indonesia also began prohibiting the use of AGPs. This ban is crucial because of the high risk of the emergence and spread of new diseases. The primary treatment for colibacillosis is antibiotics; however, recent research indicates the global scale of the appearance of E. coli strains resistant to antibiotics (Pires et al., 2022). Even in flocks of chickens that have not been exposed to antibiotics, multidrug resistance in E. coli has grown to be a serious concern (Zhang et al., 2017; Han et al., 2020; Hess et al., 2022). One of the most significant bacterial infections resistant to antibiotics in poultry in Europe is E. coli. Therefore, rather than depending only on antimicrobial treatments, investigating preventive strategies like vaccination and biosecurity measures (Paudel et al., 2024). A new therapy for multidrug-resistant bacteria has been investigated, including the use of predatory bacteria as “living antibiotics” that can combat a variety of infectious bacteria (Cavallo et al., 2021). Bdellovibrio bacteriovorus is the predatory species that has been examined the most. It exhibits a predatory lifestyle and can attack a range of species connected to endobiotic predation and human infections, especially those caused by Gram-negative bacteria (Summers and Kreft, 2022). Another therapeutic approach has been suggested: applying Bdellovibrio spp. either alone or in conjunction with bacteriophages or antibiotics, or using Bdellovibrio enzymes as antimicrobials (Bratanais et al., 2020; Pérez et al., 2020). However, to overcome resistance in target organisms and enhance effectiveness, a combination with other bacteria is required (Wu et al., 2017). Hobley et al. (2006) explored the interaction of B. bacteriovorus HD100 with mixed cultures containing both Gram-negative and Gram-positive bacteria, demonstrating its ability to reduce E. coli concentrations from approximately ~108 to ~105 cells/m. A class of predatory bacteria known as Bdellovibrio and like organisms obtain their energy and biosynthetic ingredients from live Gram-negative bacteria that they prey on (Odooli et al., 2021). Some bacteria that can be used in combination include Pseudomonas spp. and Lactobacillus spp. (Waso-Reyneke et al., 2022; Mulvey et al., 2023). Several Gram-negative pathogenic bacteria can be preyed upon and killed by B. bacteriovorus in vitro (Raghunathan et al., 2019). Therefore, this study assessed the effectiveness of combining the predatory bacterium B. bacteriovorus with Pseudomonas fluorescens and Lactobacillus acidophilus as potential new candidates for in vitro anticolibacillosis therapy. Materials and MethodsThis study aimed to assess the effectiveness of combining B. bacteriovorus, P. fluorescen, and L. acidophilus isolates in inhibiting the growth of E. coli bacteria in vitro. The research was conducted from July to October 2024 at the Institute of Tropical Disease, Universitas Airlangga. Bacterial isolatesEscherichia coli ATCC 15144 was used as the prey of B. bacteriovorus 109 J ATCC 15143 and B. bacteriovorus 109 J ATCC 15143, which combined with P. fluorescens and L. acidophilus as nutrient sources. The challenge test against E. coli and the predator attack phases were prepared following standardized methods (Ottaviani et al., 2019). Experiment procedureCultivate and incubate B. bacteriovorus on YE-NB agar at 37°C for 24 hours. Lactobacillus acidophilus was cultured on Methicillin-resistant Staphylococcus aureus (MRSA), while P. fluorescens was grown on Mueller–Hinton agar. Prepare test tubes containing 3 ml of Trypticase Soy Broth (TSB) medium. Five bacterial colonies of B. bacteriovoruses, P. fluorescens, and L. acidophilus were selected and transferred into individual sterile tubes containing TSB. The tubes were vortexed until homogeneous. The turbidity of each bacterial suspension was measured using a nephelometer, and the turbidity was adjusted to a 0.5 McFarland standard (1.5 x 108 CFU/ml). Prepare another sterile tube containing 1 ml of TSB, then add five colonies from each bacterium (B. bacteriovorus, P. fluorescens, and L. acidophilus) with their adjusted McFarland values into the tube. Vortex until homogeneous. The turbidity of the bacterial mixture was measured, and then incubated at 37°C for 24 hours. After incubation, the tube was vortexed to homogenize, and turbidity was measured again using a nephelometer. In the next step, an E. coli suspension with a known McFarland value was added into the tube containing the mixture of B. bacteriovorus, P. fluorescen, and L. acidophilus. Vortex to ensure homogeneity and incubate again at 37°C for 24 hours. After incubation, the tube was vortexed again and turbidity was measured using a nephelometer. For the best predation activation in the challenge experiment, we used a predator-prey ratio of 107 PFU/105 CFU per ml (PFU=Plaque-Forming Unit) (Ottaviani et al., 2019). ResultsThe culture media are nutrient-rich gels or liquids used to cultivate microorganisms, such as bacteria. Another name for this medium is growth media. Different types of media were used to grow different types of cells. Agar plates and broths are the most commonly used growth media for microorganisms. Certain bacteria or germs require specific media to thrive. In this study, each of the bacteria that were the objects of research was grown in media that were in accordance with the characteristics and nature of the bacteria so that they could grow optimally (Fig. 1). The expected research results at this initial stage provided evidence that each bacteria was truly a pure isolate whose potential and impact on activity were explored (Fig. 1). Several types of bacteria used in this study grew optimally and could be clearly observed according to their respective media and characteristics, including B. bacteriovorus on YE-NB agar, P. fluorescens on Mueller–Hinton agar, and L. acidophilus on MRSA.
Fig. 1. Results of bacterial isolate cultivation. (A) Escherichia coli, (B) Bacillus subtilis, (C) Bdellovibrio bacteriovorus, (D) Pseudomonas fluorescens, and (E) Lactobacillus acidophilus. The bacteria of the objects of research were grown in media that were in accordance with the characteristics and nature of the bacteria.
Fig. 2. All bacteria, including Bdellovibrio bacteriovorus, Pseudomonas fluorescens, and Lactobacillus acidophilus had grown well before being combined. These were first adjusted to a 0.5 McFarland standard using a nephelometer based on the turbidity values obtained from the three bacterial suspensions in the tubes.
Fig. 3. The combination of Bdellovibrio bacteriovorus, Pseudomonas fluorescens, and Lactobacillus acidophilus. (A) Before incubation; (B) after incubation; (C) after challenge with Escherichia coli.
Fig. 4. Pattern of predation activity of Bdellovibrio bacteriovorus toward the bacteria that comprise its prey in vitro. There was a very significant increase in the population of the combination of bacteria (B. bacteriovorus, Pseudomonas fluorescens and Lactobacillus acidophilus) (tenfold) after incubation, and then after being challenged with Escherichia coli, there was a significant decrease in. After all the bacteria had grown well, all the bacteria to be combined, including B. bacteriovorus, P. fluorescens, and L. acidophilus, were first adjusted to a 0.5 McFarland standard using a nephelometer based on the turbidity values obtained from the three bacterial suspensions in the tubes (Fig. 2). In Figure 3, it is observed that the combination of B. bacteriovorus, P. fluorescen, and L. acidophilus resulted in a bacterial count of 1.18 McFarland (1.5 × 1016) before incubation (Fig. 3A). After incubation at 37°C for 24 hours, the count increased to 10.4 McFarland (1.5 × 10160) (Fig. 3B), and following the challenge with E. coli, it decreased to 4.91 McFarland (1.5 × 1090) (Fig. 3C). The pattern of predation activity of B. bacteriovorus toward the bacteria that comprise its prey is illustrated in Figure 4. The increase in the combined bacterial population after incubation (tenfold) then a significant decrease in the bacterial population after being challenged with E. coli. DiscussionThe most extensively studied predatory bacterium is B. bacteriovorus. Numerous other Gram-negative bacteria are the prey of this particular bacterium. According to the outcomes shown in Figure 3, following a 24 hours incubation period at 37°C, the mixture of the three bacteria predatory bacterium B. bacteriovorus, P. fluorescens, and L. acidophilus showed a tenfold increase in bacterial count, from 1.18 McFarland (approximately 1.5 × 1016) to 10.4 McFarland (1.5 × 10160). This increase was attributed to the existence of Gram-negative bacteria such as P. fluorescens, which serve as a nutrient source for B. bacteriovorus (Waso et al., 2019), as Bdellovibrio utilizes the nutrients found in the cytoplasm of its prey as a carbon source and energy source for growth (Herencias et al., 2024). Conversely, when challenged with E. coli, the bacterial count of the mixture comprising the predatory bacteria B. bacteriovorus, P. fluorescens, and L. acidophilus also decreased in parallel with the reduction in the number of E. coli, from 10.4 McFarland (1.5 × 10160) to 4.91 McFarland (1.5 × 1090). This finding is consistent with the behavior of Bdellovibrio, which takes turns between two phases in its life cycle. This bacteria does not develop during the free-living assault phase; instead, it seeks out prey. It can reach up to 160 μm s-¹, or roughly 100 body lengths s-¹ in swims, which is faster than most bacteria (Summers and Kreft, 2022). Because it depends on its prey for nutrition, its quick movement requires a high metabolic rate, which causes it to lose viability within 10 hours if no prey is found (Hobley et al., 2020). Typically, after locating its prey, Bdellovibrio assesses its suitability for several minutes (Hobley et al., 2006). If the prey is deemed suitable, the bacterium enters the periplasmic space through pores in the peptidoglycan layer and outer membrane, losing its flagellum in the process (Starr and Baigent, 1966). Bdellovibrio kills the prey as it enters the periplasm, allowing the cytoplasm contents to spill into the periplasmic space (Romo et al., 1992). Additionally, the bacterium alters the peptidoglycan of the prey, causing the prey cell to round into a “bdelloplast.” Instead of division during the bdelloplast phase, Bdellovibrio uses the released nutrients to grow as a long filament (Lambert et al., 2006). The filament divides into new cells after the nutrients run out, creating as many offspring as the resource permit. This usually results in three to six new predators for every E. coli cell (Seidler and Starr, 1969). Under normal binary fission, this bacterium would only be capable of producing offspring in powers of two (2^n), which could potentially result in unused prey resources if those resources are sufficient for five but not eight progeny. To escape and find new prey, freshly created Bdellovibrio cells lyse the remains of the prey cell and develop flagella. Additionally, according to Gao et al. (2022), because L. acidophilus lowers intestinal pH and produces metabolites, it can help manage the balance of gut flora (Tegegne and Kebede, 2022). Many gut pathogens prefer a pH of neutral or slightly alkaline. The metabolism of L. acidophilus produces lactic acid, which lowers pH and prevents pathogenic bacteria from growing and reproducing (Gao et al., 2022). Furthermore, enzymes like azo reductase, nitro reductase, and β-glucosidase are produced by pathogenic microbes and catalyze the transformation of procarcinogenic precursors into carcinogens (Goldin and Gorbach, 1980, 1984). Lactobacillus acidophilus decreases the enzymatic activity of these harmful microbes in addition to preventing their proliferation and lowering the synthesis of these enzymes (Goldin and Gorbach, 1984; Chang et al., 2012). Additionally, a crucial mechanism by which L. acidophilus competes with pathogenic bacteria for attachment sites impairs pathogenic bacterial functions, thereby preventing their invasion of host cells (Singh et al., 2013). Surface-layer proteins, extracellular polysaccharides, and lipoteichoic acids on the surface of many L. acidophilus strains can compete with pathogens for adhesion (Kopp-Hoolihan, 2001; Tegegne and Kebede, 2022). ConclusionThe predatory bacterium B. bacteriovorus, when combined with P. fluorescens and L. acidophilus, has been shown to increase the population of the predator bacteria tenfold at 37°C within 24 hours and effectively reduce the number of E. coli. However, if these predatory bacteria do not obtain nutrients and energy from Gram-negative bacteria, their population will gradually decline over time. AcknowledgmentsWe are indebted to PT. Centra Biotech Indonesia for the arrangement for their assistance in providing of the sample as well as laboratory members. We thank the anonymous reviewers for their careful reading of our manuscript and their many insightful comments and suggestions, which have helped improve the quality of our manuscript. Conflicts of interestThe authors declare that they have no conflict of interest. FundingWe thank the Directorate General of Research, Technology, and Higher Education for their financial support through the Matching Fund Program Kedaireka Batch 3, 2024. We thank the Rector of Universitas Airlangga for providing additional funding for this study. Author’s contributionAll authors contributed to the study’s conception and design. Material preparation, data collection, and analysis were performed by all authors: laboratory processing of samples (EBA, MY, ISH, GMS). The first draft of the manuscript was written by EBA and MY, and subsequently revised by MY and EBA. All authors read and approved the final manuscript. Data availabilityEscherichia coli ATCC 15144 and B. bacteriovorus 109 J ATCC 15143 specimens were cultured and maintained in Microbiology Laboratory of Faculty of Veterinary Medicine, Universitas Airlangga. The P. fluorescens and L. acidophilus specimens obtained in this study are available from the same laboratory. The data that support the findings of this study are available from the corresponding author upon reasonable request. ReferencesAbalaka, S.E., Sani, N.A., Idoko, I.S., Tenuche, O.Z., Oyelowo, F.O., Ejeh, S.A. and Enem, S.I. 2017. Pathological changes associated with an outbreak of colibacillosis in a commercial broiler lock. Sokoto J. Vet. Sci. 15, 95–102; doi: 10.4314/sokjvs.v15i3.14. Bratanais, E., Andersson, T., Lood, R. and Bukowska-Faniband, E. 2020. Biotechnological potential of Bdellovibrio and like organisms and their secreted enzymes. Front. Microbiol. 11, 662; doi: 10.3389/fmicb.2020.00662. Chang, J., Shim, Y.Y., Cha, S.K., Reaney, M.J.T. and Chee, K.M. 2012. Effect of Lactobacillus acidophilus KFRI342 on the development of chemically induced precancerous growth in the rat colon. J. Med. Microbiol. 61, 361–368. Cavallo, F.M., Jordana, L., Friedrich, A.W., Glasner, C. and van Dijl, J.M. 2021. Bdellovibrio bacteriovorus: a potential ‘living antibiotic’ to control bacterial pathogens. Crit. Rev. Microbiol. 47, 630–646; doi: 10.1080/1040841X.2021.1908956. De Brito, B.G., Gaziri, L.C.J. and Vidotto, M.C. 2003. Virulence factors and clonal relationships among Escherichia coli strains isolated from broiler chickens with cellulitis. Infect. Immun. 71, 4175; doi: 10.1128/IAI.71.7.4175-4177.2003. Gao, H., Li, X., Chen, X., Hai, D., Wei, C., Zhang, L. and Li, P. 2022. The functional roles of Lactobacillus acidophilus in different physiological and pathological processes. J. Microbiol. Biotechnol. 32(10), 1226–1233; doi: 10.4014/jmb.2205.05041. Ghunaim, H., Abu-Madi, M.A. and Kariyawasam, S. 2014. Advances in vaccination against avian pathogenic Escherichia coli respiratory disease: potentials and limitations. Vet. Microbiol. 172, 13–22; doi: 10.1016/j.vetmic.2014.04.019. Goldin, B.R. and Gorbach, S.L. 1980. Effects of Lactobacillus acidophilus dietary supplements on 1,2-dimethylhydrazine dihydrochloride-induced intestinal cancer in rats. J. Natl. Cancer Inst. 64, 263–265. Goldin, B.R. and Gorbach, S.L. 1984. Effects of milk and Lactobacillus supplementation on human intestinal bacterial enzyme activity. Am. J. Clin. Nutr. 39, 756–761. Han, T., Zhang, Q., Liu, N., Wang, J., Li, Y., Huang, X., Liu, J., Wang, J., Qu, Z. and Qi, K. 2020. Changes in the antibiotic resistance of Escherichia coli during the broiler feeding cycle. Poult. Sci. 99(12), 6983–6989; doi: 10. 1016/j.psj.2020.06.068. Herencias, C., Rivero-Buceta, V., Salgado, S., Hernández-Herreros, N., Baquero, F., del Campo, R., Nogales, J. and Prieto, M.A. 2024. Bdellovibrio’s prey-independent lifestyle is fueled by amino acids as a carbon source. Appl. Microbiol. Biotechnol. 108, 422; doi: 10.1007/s00253-024-13250-y. Hess, C., Troxler, S., Jandreski-Cvetkovic, D., Zloch, A. and Hess, M. 2022. Escherichia coli isolated from organic laying hens reveal high antimicrobial resistance despite no antimicrobial treatments. Antibiotics (Basel) 11(4), 467; doi: 10.3390/antibiotics11040467. Hobley, L., King, J.R. and Sockett, R.E. 2006. Bdellovibrio predation in the presence of decoys: three-way bacterial interactions revealed by mathematical and experimental analyses. Appl. Environ. Microbiol. 72, 6757–6765; doi: 10.1128/AEM.00844-06. Hobley, L., Summers, J.K., Till, R., Milner, D.S., Atterbury, R.J., Stroud, A., Capeness, M.J., Gray, S., Leidenroth, A., Lambert, C., Connerton, I., Twycross, J., Baker, M., Tyson, J., Kreft, J.U. and Sockett, R.E. 2020. Dual predation by bacteriophages and Bdellovibrio can eradicate E. coli prey in situations where single predation cannot. J. Bacteriol. 202, 1–32; doi: 10.1128/JB.00629-19. Kathayat, D., Lokesh, D., Ranjit, S. and Rajashekara, G. 2021. Avian pathogenic Escherichia coli (APEC): an overview of virulence and pathogenesis factors, zoonotic potential, and control strategies. Pathogens 10(4), 467; doi: 10.3390/pathogens10040467. Kika, T.S., Cocoli, S., Pelić, D.L., Puvača, N., Lika, E. and Pelić, M. 2023. Review: colibacillosis in modern poultry production. J. Agron. Technol. Eng. Manag. 6(6), 975–987; doi: 10.55817/YZFA3391. Kopp-Hoolihan, L. 2001. Prophylactic and therapeutic uses of probiotics: a review. J. Am. Diet Assoc. 101, 229–238. Kostadinović, L. and Lević, J. 2018. Effects of phyto additives in poultry and pigs diseases. J. Agron. Technol. Eng. Manag. 1, 1–7. Kostadinovic, L.M., Pavlovski, Z. and Pavkov, S. 2001. Effect of amprolium on lipid peroxidation and the activity of superoxide dismutase in broiler blood and liver. Arch. Geflüelkd. 65, 118–122. Koutsianos, D., Athanasiou, L.V., Mossialos, D., Franzo, G., Cecchinato, M. and Koutoulis, K.C. 2022. Serotype prevalence of Escherichia coli strains isolated from layer poultry in Greece and their interactions with other infectious agents. Vet. Sci. 9, 152; doi: 10.3390/vetsci9040152. Lambert, C., Morehouse, K.A., Chang, C.Y. and Sockett, R.E. 2006. Bdellovibrio: growth and development during the predatory cycle. Curr. Opin. Microbiol. 9, 639–644; doi: 10.1016/j.mib.2006.10.002. Meena, M., Swapnil, P., Zehra, A., Aamir, M., Dubey, M.K., Patel, C.B. and Upadhyay, R.S. 2019. Chapter 11 - Virulence factors and their associated genes in microbes. In New and future developments in microbial biotechnology and bioengineering. Eds., Singh, H.B., Gupta, V.K. and Jogaiah, S. Amsterdam, Netherlands: Elsevier, pp: 181–208. ISBN 978-0-444-63503-7. Mellata, M. 2013. Human and avian extraintestinal pathogenic Escherichia coli: infections, zoonotic risks, and antibiotic resistance trends. Foodborne Pathog. Dis. 10, 916–932; doi: 10.1089/fpd.2013.1533. Mulvey, K., Brosnan, K., Galvin, M., Mohr, S., Muldowney, L., Oser, M. and Williams, L.E. 2023. Parallel evolution in predatory Bdellovibrio sp. NC01 during long-term coculture in a single prey strain. Appl. Environ. Microbiol. 89(1), 1–17; doi: 10.1128/aem.01776-22. Odooli, S., Roghanian, R. and Ghasemi, Y. 2021. Predatory and biocontrol potency of Bdellovibrio bacteriovorus toward phytopathogenic strains of Pantoea sp. And Xanthomonas campestris in the presence of exo-biopolymers: in vitro and in vivo assessments. Int. Microbiol. 24, 399–413. Ottaviani, D., Pieralisi. S., Angelico, G., Mosca, F., Tiscar, P.G., Rocchegiani, E., Scuota, S., Petruzzelli, A., Fisichella, S., Blasi, G. and DiRaimo, E. 2019. Bdellovibrio bacteriovorus to control Escherichia coli on meat matrices. IJFST 55(3), 988–994; doi: 10.1111/ijfs.14355. Paudel, S., Apostolakos, I., Ngom, R.V., Tilli, G., de Carvalho Ferreira, H.C. and Piccirillo, A. 2024. A systematic review and meta-analysis on the efficacy of vaccination against colibacillosis in broiler production. PLoS One 19(3), e0301029; doi: 10.1371/journal.pone.0301029. Pérez, J., Contreras-Moreno, F.J., Marcos-Torres, F.J., Moraleda-Muñoz, A. and Muñoz-Dorado, J. 2020. The antibiotic crisis: how bacterial predators can help. Comput. Struct. Biotechnol. J. 18, 2547–2555; doi: 10.1016/j.csbj.2020.09.010. Pires, J., Huisman, J.S., Bonhoeffer, S. and Van Boeckel, T.P. 2022. The increase in antimicrobial resistance in Escherichia coli in food animals between 1980 and 2018 was assessed using genomes from public databases. J. Antimicrob. Chemother. 77(3), 646–655; doi: 10.1093/jac/dkab451. Raghunathan, D., Radford, P.M., Moore, C., Till, R., Tighe, P.J., Wheatley, S.P., Spckett, R.E. and Tyson, J. 2019. Engulfment, persistence, and fate of Bdellovibrio bacteriovorus predators inside human phagocytic cells informs their future therapeutic potential. Sci. Rep. 9, 4293; doi: 10.1038/s41598-019-40223-3. Romo, A.J., Ruby, E.G. and Saier, M.H.J. 1992. Effect of Bdellovibrio bacteriovorus infection on the phosphoenol pyruvate: sugar phosphotransferase system in Escherichia coli: evidence for activation of cytoplasmic proteolysis. Res. Microbiol. Paris 143, 5–14; doi: 10.1016/0923-2508(92)90029-N. Rybak, B., Krawczyk, B., Furmanek-Blaszk, B., Wysocka, M., Fordon, M., Ziolkowski, P., Meissner, W., Stepniewska, K. and Sikorska, K. 2022. Antibiotic resistance, virulence, and phylogenetic analysis of Escherichia coli strains from free-living birds in human habitats. Plos One 17, e0262236; doi: 10.1371/journal.pone.0262236. Rybak, M.J., Zasowski, E., Trinh, T. and Lagnf, A. M. 2017. Risk Factors and Outcomes for Bloodstream Infections (BSI) Among Patients with Acute Bacterial Skin and Skin Structure Infections (ABSSSI). Open Forum Infect. Dis. 4(suppl_1), S110-S111; doi: 10.1093/ofid/ofx163.117 Seidler, R.J. and Starr, M.P. 1969. Factors affecting the intracellular parasitic growth of Bdellovibrio bacteriovorus developing within Escherichia coli. J. Bacteriol. 97, 912–923; doi: 10.1128/jb.97.2.912-923.1969. Singh, V.P., Sharma, J., Babu, S., Rizwanulla and Singla, A. 2013. Role of probiotics in health and disease: a review. Pak. Med. Assoc. 63, 253–257. Sora, V.M., Meroni, G., Martino, P.A., Soggiu, A., Bonizzi, L. and Zecconi, A. 2021. Extraintestinal pathogenic Escherichia coli: virulence factors and antibiotic resistance. Pathogens 10, 1355; doi: 10.3390/pathogens10111355. Starr, M.P. and Baigent, N. 1966. Parasitic interaction of Bdellovibrio bacteriovorus with other bacteria. J. Bacteriol. 91, 2006–2017; doi: 10.1128/jb.91.5.2006-2017.1966. Summers, J.K. and Kreft, J.U. 2022. Predation strategies for the bacterium Bdellovibrio bacteriovorus result in overexploitation and bottlenecks. Appl. Environ. Microbiol. 88, e0108221. Tegegne, B.A. and Kebede, B. 2022. Probiotics and their prophylactic and therapeutic applications in human health development: a review of the literature. Heliyon 8, e09725. Waso, M., Khan, S. and Khan, W. 2019. Assessment of predatory bacteria and prey interactions using culture-based methods and EMA-qPCR. Microbiol. Res. 228, 126305–12630. Waso-Reyneke, M., Khan, S. and Khan, W. 2022. Interactions of Bdellovibrio bacteriovorus with gram-negative and gram-positive bacteria in dual species and polymicrobial communities. Microorganisms 10, 793; doi: 10.3390/microorganisms10040793. Weerts, E.A.W.S., Matthijs, M.G.R., Bonhof, J., van Haarlem, D.A., Dwars, R.M., Gröne, A., Verheije, M.H. and Jansen, C.A. 2021. The contribution of immune enhanced colibacillosis upon preceding viral infection of the respiratory tract in broiler chicken in a dual infection model. Vet. Immunol. Immunopathol. 238, 110276; doi: 10.1016/j.vetimm.2021.110276. Wu, B., Rong, W. and Fane, A.G. 2017. The roles of bacteriophages in membrane based water and wastewater treatment processes: a review. Water Res. 110, 120–132; doi: 10.1016/j.watres.2016.12.004. Zhang, P., Shen, Z., Zhang, C., Song, L., Wang, B., Shang, J., Yue, X., Qu, Z., Li, X., Wu, L. and Zheng, Y. 2017. Surveillance of antimicrobial resistance to Escherichia coli in chickens and swine in, China, 2008–2015. Vet. Microbiol. 203, 49–55; doi: 10.1016/j.vetmic.2017.02.008. | ||
| How to Cite this Article |
| Pubmed Style Aksono EB, Yunus M, Hamid IS, Sari GM. Effectiveness of predatory bacterium Bdellovibrio bacteriovorus in combination with Pseudomonas fluorescens and Lactobacillus acidophilus as candidates for in vitro anticolibacillosis. Open Vet. J.. 2025; 15(3): 1379-1386. doi:10.5455/OVJ.2025.v15.i3.29 Web Style Aksono EB, Yunus M, Hamid IS, Sari GM. Effectiveness of predatory bacterium Bdellovibrio bacteriovorus in combination with Pseudomonas fluorescens and Lactobacillus acidophilus as candidates for in vitro anticolibacillosis. https://www.openveterinaryjournal.com/?mno=234167 [Access: January 25, 2026]. doi:10.5455/OVJ.2025.v15.i3.29 AMA (American Medical Association) Style Aksono EB, Yunus M, Hamid IS, Sari GM. Effectiveness of predatory bacterium Bdellovibrio bacteriovorus in combination with Pseudomonas fluorescens and Lactobacillus acidophilus as candidates for in vitro anticolibacillosis. Open Vet. J.. 2025; 15(3): 1379-1386. doi:10.5455/OVJ.2025.v15.i3.29 Vancouver/ICMJE Style Aksono EB, Yunus M, Hamid IS, Sari GM. Effectiveness of predatory bacterium Bdellovibrio bacteriovorus in combination with Pseudomonas fluorescens and Lactobacillus acidophilus as candidates for in vitro anticolibacillosis. Open Vet. J.. (2025), [cited January 25, 2026]; 15(3): 1379-1386. doi:10.5455/OVJ.2025.v15.i3.29 Harvard Style Aksono, E. B., Yunus, . M., Hamid, . I. S. & Sari, . G. M. (2025) Effectiveness of predatory bacterium Bdellovibrio bacteriovorus in combination with Pseudomonas fluorescens and Lactobacillus acidophilus as candidates for in vitro anticolibacillosis. Open Vet. J., 15 (3), 1379-1386. doi:10.5455/OVJ.2025.v15.i3.29 Turabian Style Aksono, Eduardus Bimo, Muchammad Yunus, Iwan Sahrial Hamid, and Gadis Meinar Sari. 2025. Effectiveness of predatory bacterium Bdellovibrio bacteriovorus in combination with Pseudomonas fluorescens and Lactobacillus acidophilus as candidates for in vitro anticolibacillosis. Open Veterinary Journal, 15 (3), 1379-1386. doi:10.5455/OVJ.2025.v15.i3.29 Chicago Style Aksono, Eduardus Bimo, Muchammad Yunus, Iwan Sahrial Hamid, and Gadis Meinar Sari. "Effectiveness of predatory bacterium Bdellovibrio bacteriovorus in combination with Pseudomonas fluorescens and Lactobacillus acidophilus as candidates for in vitro anticolibacillosis." Open Veterinary Journal 15 (2025), 1379-1386. doi:10.5455/OVJ.2025.v15.i3.29 MLA (The Modern Language Association) Style Aksono, Eduardus Bimo, Muchammad Yunus, Iwan Sahrial Hamid, and Gadis Meinar Sari. "Effectiveness of predatory bacterium Bdellovibrio bacteriovorus in combination with Pseudomonas fluorescens and Lactobacillus acidophilus as candidates for in vitro anticolibacillosis." Open Veterinary Journal 15.3 (2025), 1379-1386. Print. doi:10.5455/OVJ.2025.v15.i3.29 APA (American Psychological Association) Style Aksono, E. B., Yunus, . M., Hamid, . I. S. & Sari, . G. M. (2025) Effectiveness of predatory bacterium Bdellovibrio bacteriovorus in combination with Pseudomonas fluorescens and Lactobacillus acidophilus as candidates for in vitro anticolibacillosis. Open Veterinary Journal, 15 (3), 1379-1386. doi:10.5455/OVJ.2025.v15.i3.29 |